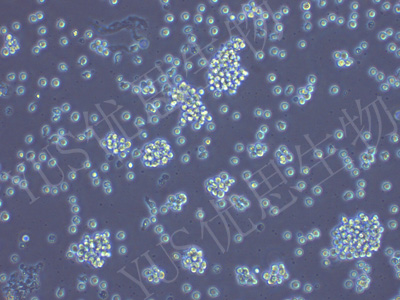

产品中心
产品中心
-

Hs 578T 人乳腺癌细胞(STR鉴定)
货号:YLH212规格: 1*10^6 -

TTA1 人甲状腺癌细胞(STR鉴定)
货号:YLH213规格: 1*10^6 -

NCI-H524 人小细胞肺癌细胞(STR鉴定)
货号:YLH214规格: 1*10^6 -

Ishikawa 人子宫内膜癌细胞(STR鉴定)
货号:YLH215规格: 1*10^6 -

A875 人黑色素瘤细胞(STR鉴定)
货号:YLH216规格: 1*10^6 -

MHCC-97H 人高转移性肝癌细胞(STR鉴定)
货号:YLH217规格: 1*10^6 -

NK-92MI 人恶性非霍奇金淋巴瘤患者的自然杀伤细胞(STR鉴定)
货号:YLH220规格: 1*10^6 -

TPC-1 人甲状腺癌细胞(STR鉴定)
货号:YLH221规格: 1*10^6 -
D341Med 人脑髓母细胞瘤细胞(STR鉴定)
货号:YLH222规格: 1*10^6 -

KU812 人外周血嗜碱性白血病细胞(STR鉴定)
货号:YLH223规格: 1*10^6 -

WRL68 人正常肝细胞(STR鉴定)
货号:YLH225规格: 1*10^6 -

CAL-27 人舌鳞癌细胞(STR鉴定)
货号:YLH226规格: 1*10^6
在线咨询
Online consultation

关注微信公众号


